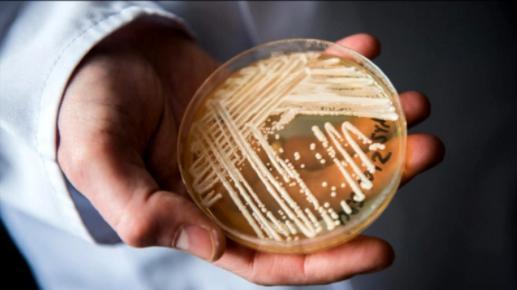

2016-2022 All Rights Reserved.平安財經網.復制必究 聯系QQ 備案號:
本站除標明“本站原創”外所有信息均轉載自互聯網 版權歸原作者所有。
美國疾病控制和預防中心近期發布了一則通告稱,目前耳念珠菌正在美國境內大面積傳播。截止到目前,美國已經有一半以上的地區都發現了耳念珠菌,已經給美國的公共衛生體系造成了嚴重的危險。根據美國疾控中心的研究報告顯示耳念珠菌其主要的攻擊對象是免疫系統比較弱的老年人,而對于常見的抗真菌藥物對于耳念珠菌是沒有任何效果。從2019年到2020年,耳念珠菌僅僅一年的時間,感染人數增加了59%,達到了756人,2021年感染人數為1471人,2022年感染人數為2377人。
耳念珠菌大范圍傳播:
根據美國疾病控制和預防中心的數據顯示,目前感染了耳念珠菌的患者會有50%以上的患者在90天之內死亡。如果是住院病人感染之后,有30%~70%會死亡,對于目前的住院死亡人數目前還沒有研究出這些人的死亡原因是否和耳念珠菌有關系,但是導致這些病人死亡的直接原因是因為耳念珠菌的感染。

這些病人在感染耳念珠菌之后可能會加速死亡時間,目前所要面臨的最大問題是這些感染大多數都發生在患有疾病的人群身上。目前首要的問題是要在醫院內建立防范措施,防止病菌傳到醫院的重癥監護病房,但是由于耳念珠菌有著非常強的生存能力和繁殖能力,進行消除有著比較大的難度。這種真菌會長期停留在衣物和物品上,并且能夠通過病人和被污染的物體進行傳播。

不能夠有效的進行徹底清除,而念珠菌對于目前醫療機構大多數的消毒劑有著比較強的耐藥性,有醫療專家稱新冠疫情加重了耳念珠菌的傳播速度。各個醫療機構對于新冠病毒的防護,遠遠超過了耳念珠菌這才導致了此真菌的大范圍傳播。
2016-2022 All Rights Reserved.平安財經網.復制必究 聯系QQ 備案號:
本站除標明“本站原創”外所有信息均轉載自互聯網 版權歸原作者所有。